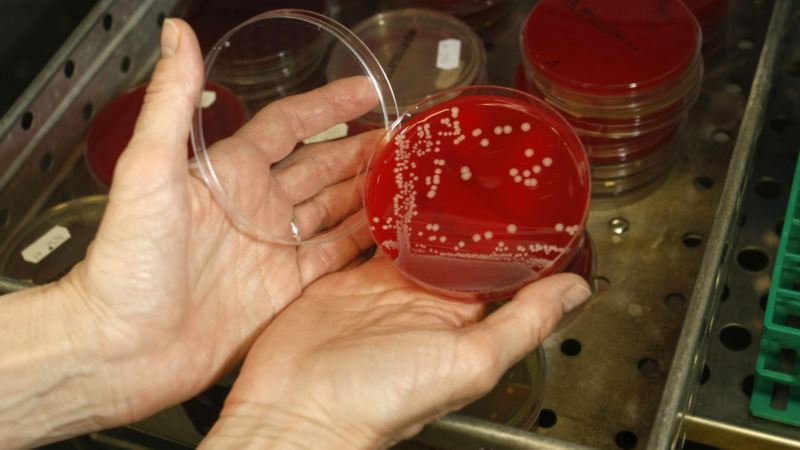
mrsa

Vremenska prognoza za Hrvatsku za 15.01.2014
U većini krajeva oblačno povremeno s kišom, osobito u Dalmaciji gdje će mjestimice biti i obilnije kiše Na sjevernom Jadranu djelomično razvedravanje, a krajem dana i u sjeverozapadnim krajevima uz mogućnost magle. Vjetar slab do umjeren sjeverni i sjeveroistočni, na… Read More »Vremenska prognoza za Hrvatsku za 15.01.2014